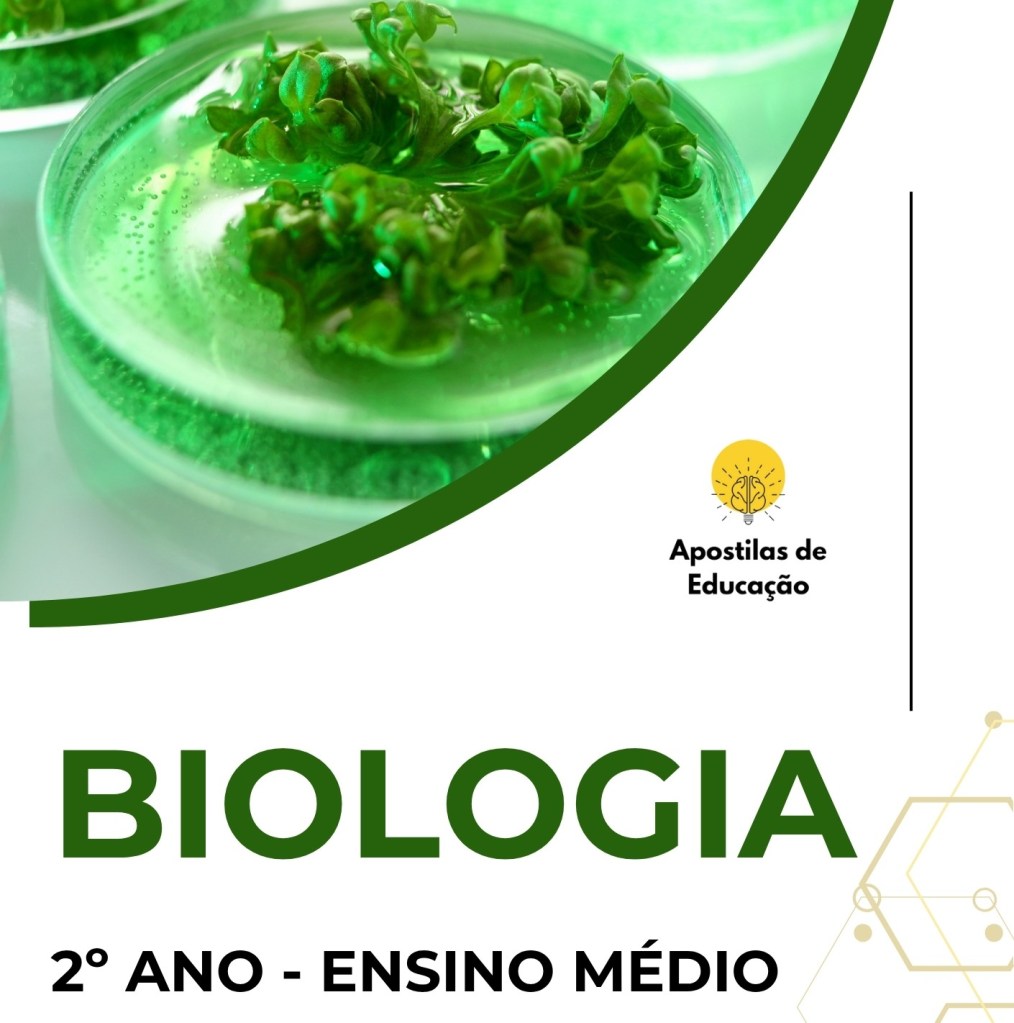

As apostilas de Biologia para o Ensino Médio reúnem planos de aula com textos informativos, questões abertas e exercícios de fixação com respostas, além de atividades práticas. O material visa aprofundar os conhecimentos sobre os processos biológicos, promover o pensamento crítico e estimular a compreensão das relações entre ciência, ambiente, saúde e sociedade.
Confira nossas apostilas de acordo com a BNCC (Base Nacional Comum Curricular), separadas nos formatos Bimestral e Trimestral:
Bimestral
Biologia 1º Ano

Biologia 2º Ano
Biologia 3º Ano

Trimestral
Biologia 1º Ano

Biologia 2º Ano

Biologia 3º Ano

